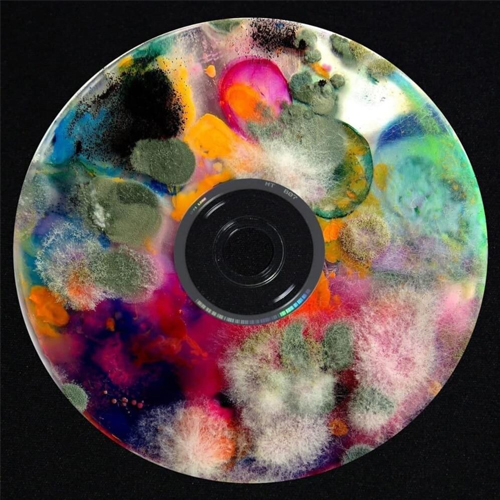

Музыкальные новинки недели: космические Coldplay, терапевтическая Bebe Rexha и метеросексуальные Imagine Dragons
Собрали самые интересные музыкальные релизы этой недели, которые скрасят горечь будних дней после майских
Bebe Rexha — альбом «Better Mistakes»

Биби Рекса описала свой альбом как «настоящую неуверенность в себе». Тут тебе и треки о психическом здоровье, и о любви к себе, и даже о самосаботаже — короче говоря, девочки, все как мы любим, и никакой поход к психологу не нужен.
Rag’n’Bone Man — альбом «Life By Misadventure»

К сожалению, артисту не удалось превзойти самого себя и свой дебютный альбом «Human» 2016 года — в новом релизе сплошные любовные баллады и кантри звучания с одинаковой эмоциональностью в каждом слоге.
OneRepublic — песня «Run»

К треку особых претензий нет, разве что он ничем не отличается от любой другой песни группы, а вот к клипу — вагон и маленькая тележка. Странную игру в переодевание затеяла OneRepublic, абсолютно несмешную и крайне оскорбительную. Видимо, ребята не в курсе, что они уже давно не в нулевых и после подобных видео можно ощутить на себе все прелести «культуры отмены».
Coldplay — песня «Higher Power»

Группа буквально запустила трек в космос — может, поэтому «Higher Power» и звучит так, будто бы была записана в эпоху освоения космоса, а может, ребята просто решили вернуться к фирменной электроэйфории. Ну что же, скоро узнаем, ведь релиз нового альбома группы намечен на этот год.
Хаски — песня «NPC»

Нам не очень близко звучание трека, но вот отсылка к разбойникам из «Бременских музыкантов» очень понравилась — да-да, та самая, что кроется в строках со словами «Уляля, улюлю». Таким ностальгическим способом Хаски выразил свое отношение к власти, ограничивающей свободу слова, пресекающий любые попытки мятежа и поведения, не соответствующего генеральной линии власти.
Boulevard Depo & JEEMBO — песня «Manhunt»
Припев «Manhunt» звучит как жесткая версия трека «My Humps» группы The Black Eyed Peas. Вот только за ним не следуют слова о чарующий силе так называемых Humps, а начинается рывковая читка обо всем и ни о чем сразу.
P!nk — видео «All I Know So Far»
Несмотря на перенасыщенную сюжетную линию клипа, он получился достаточно неинтересным, равно как и песня (очередной монотонный гибрид поп-рока). Лучшее, что есть в этом релизе, — мираж певицы Шер, который выглядит одновременно роскошно и кринжово.
Imagine Dragons — видео «Cutthroat»
Если отбросить легкий шлейф метросексуальности, то у группы получился очень стильный клип с Оливией Манн и отсылками к старым хитам. Видео идеально олицетворяет наш первый рабочий день после майских праздников — полный раздрай.
Noel Gallagher — видео «We’re On Our Way Now»
Вы смотрели фильм «500 дней лета» 2009 года? Так вот, это он, но только в ч/б и с Мэттом Смитом из «Доктора Кто» в главной роли. Мы побежали заваривать себе кофе и в миллионный раз смотреть клип, что и вам советуем сделать. Услышимся на следующей неделе, оревуар!